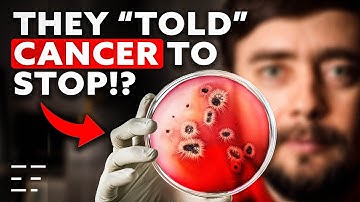
Bioelectric Fields: A Paradigm Shift In Biology | Prof. Michael Levin

⬇ DOWNLOAD NOW
Kalau muncul iklan pop-up, tutup lalu klik tombol kembali
Download lagu Lightning and AI w/ Michael Levin secara gratis hanya untuk keperluan promosi. Dukung artis favorit kamu dengan membeli musik original di iTunes atau platform resmi lainnya.
 Michael Levin: The electrical blueprints that orchestrate life | TED
Michael Levin: The electrical blueprints that orchestrate life | TED
 "Unconventional Embodiments: model systems & strategies addressing mind-blindness" by Michael Levin
"Unconventional Embodiments: model systems & strategies addressing mind-blindness" by Michael Levin
 He Showed Too Much… A Discovery Too Dangerous to Expose
He Showed Too Much… A Discovery Too Dangerous to Expose
 Toward AI-Driven Discovery of Electroceuticals - Dr. Michael Levin
Toward AI-Driven Discovery of Electroceuticals - Dr. Michael Levin
 Tarin Ziyaee, Michael Levin and Josh Bongard | Embodied Natural Intelligence VS Embodied AI
Tarin Ziyaee, Michael Levin and Josh Bongard | Embodied Natural Intelligence VS Embodied AI
Bioelectric Fields: A Paradigm Shift In Biology | Prof. Michael Levin
Bioelectric Fields: A Paradigm Shift In Biology | Prof. Michael Levin
 "The Embodied Mind of a New Robot Scientist" by Michael Levin
"The Embodied Mind of a New Robot Scientist" by Michael Levin
 How bioelectricity could regrow limbs and organs, with Michael Levin
How bioelectricity could regrow limbs and organs, with Michael Levin